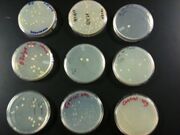

Uploads by Thomas J. Burkett
From OpenWetWare
Jump to navigationJump to search
This special page shows all uploaded files.
| Date | Name | Thumbnail | Size | Description |
|---|---|---|---|---|
| 00:58, 6 November 2014 | Openwet1.pdf (file) | 50 KB | November 15th Lab Notes | |
| 18:07, 26 March 2013 | Build a bug transformants 2 3 23 2013.JPG (file) | |
1.15 MB |